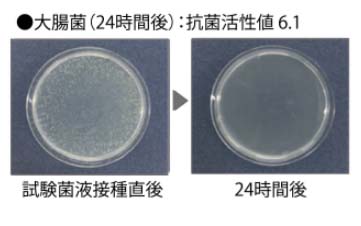
高い抗菌性能

検索
閉じる
2025.09.03物置やガレージ、ユニットハウスへ設置されたシャッターについてのご注意
カテゴリ

穏やかで、心地よいプライベート空間の実現
部屋の延長として外部空間を確保する為に有効なウッドデッキ。
「テクモク」なら環境に配慮しながら、ご家族に憩いの空間をご提供いたします。日よけ、雨よけ、省エネ効果のあるオーニングとセットで設置すればその空間はさらに心地よいプライベート空間へとグレードアップ!!
テクモクとは?
テクモクは「再生材を利用した建築用製品」としてエコマーク認証を受けています。
エコマークは(財)日本環境協会が環境保全に役立つ商品を認定し、その商品に表示できるマークです。

グリーン購入法に基づく「環境物品等の調達の推進に関する基本方針」において「木材・ブラスチック再生複合材製品」が特定調達品目として指定されています。 テクモクは特定調達品目としての判断の基準に適合しています。
テクモクの2つの特徴
腐らない
腐朽菌による耐朽試験において、天然木に比べ朽ちにくいと判定されています。


白蟻に食べられない
木粉を樹脂がつつみこむ構造のため、白蟻に食害されることはありません。


変色しにくい
設置した初期段階では天然木同様、紫外線によりある程度の退色はしますが、その後大きな変化はありません。


大規模補修が不要
天然木と比べ傷みにくいため、数年ごとの塗装や大規模なメンテナンスの必要はなく、その分のランニングコストはかかりません。


お手入れ簡単
表面の汚れは雑巾などで拭き取れ、たとえばタバコの火の焦げなどもサンドペーパーで長手方向に搾り取ることができます。

高い抗菌性能
製品の表面における細菌の増殖を抑制します。

トゲ・ささくれがない
木質原料は数100ミクロンまで微粉砕して成形加工しているため、天然木のようにトゲ、ささくれはできません。
安全・安心素材
ノンホルムアルデヒドの安全素材で、防腐剤処理や有害な塗料は一切使用していません。
遮熱デッキ材表面が熱くなりにくい新機能で、夏場の表面温度の上昇を抑えることができるため、さらに快適に使用できます。
表面温度の上昇を「4℃」抑制
遮熱デッキ材は夏場の直射日光下で表面温度の上昇を約4℃抑制します。この約4℃の表面温度抑制効果で、やけどのリスクを大幅に低減することができます。


右のグラフはやけどの原因となる温度と接触時間の関係を示したグラフです。表面温度が60℃の場合、約5秒間接触し続けるとやけどの可能性があることを示しています。表面温度が56℃の場合その時間は約10秒となり、約4℃の表面温度抑制効果でやけどのリスクが低減することがわかります。
デッキフェンス・門扉あらゆる建物にフィットするシンプルなデザインで、デッキまわりを彩りながら利便性をもたらします。

利便性を向上させる門扉
「お子さまやペットが外に飛び出ないようにしたい」などのニーズにお応えして、デッキフェンスに門扉の取付けが可能になりました。
標準付属金物


オプション部品

フェンスバリエーションが豊富素材の特長を最大限に生かしたシンプルなデザイン。お子さまがよじ登りにくい縦格子や、目隠し効果を期待できるダイヤなど、5タイプからお選びいただけます。


テクモクの施工事例
テクモクの高い安全性テクモクは環境性能と品質、安全性から保育園、幼稚園、公園、公共施設などでも使用されています。
※参考価格には取付工事費が含まれております。(基礎工事、搬入費は含みません。)
※既存製品の取り外し及び廃材処分費は別途お見積させていただきます。
※現地調査の結果、表示価格の他に別途付帯工事費が発生することがあります。
デッキ間口360cm×出幅180cm×高さ35cm
遮熱仕様デッキ
標準価格
460,000円/セット
デッキ間口360cm×出幅180cm×高さ35cm
ステップ間口120cm×出幅33cm×高さ17.5cm
遮熱仕様デッキ
標準価格
550,000円/セット
デッキ間口360cm×出幅180cm×高さ35cm
ステップ間口120cm×出幅33cm×高さ17.5cm
フェンス(ダイヤ格子)フェンス高さ90cm
遮熱仕様デッキ
標準価格
1,093,000円/セット